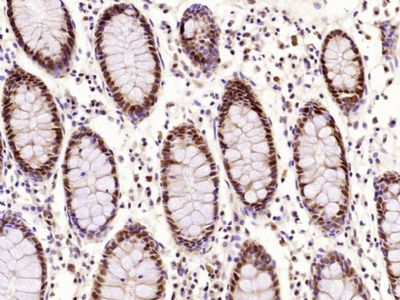
产品细节图片4

相关产品推荐更多 >
万千商家帮你免费找货
0 人在求购买到急需产品
- 详细信息
- 文献和实验
- 技术资料
- 供应商:
上海联迈生物工程有限公司
- 库存:
大量
- 目录编号:
LM-33035M
- 克隆性:
多克隆
- 抗原来源:
Rabbit
- 保质期:
1年
- 抗体英文名:
PCNA
- 抗体名:
增殖细胞核抗原单克隆抗体
- 宿主:
Rabbit
- 适应物种:
Human, Mouse, Rat,
- 免疫原:
KLH conjugated synthetic peptide derived from human PCNA:
- 亚型:
IgG
- 形态:
Lyophilized or Liquid
- 应用范围:
WB=1:500-1000 IHC-P=1:400-800 IHC-F=1:400-800 (石蜡切片需做抗原修复)
- 浓度:
1mg/ml
- 保存条件:
Store at -20 °C
- 规格:
50ul 100ul
| 英文名称 | PCNA |
| 中文名称 | 增殖细胞核抗原单克隆抗体 |
| 别 名 | Cyclin; DNA polymerase delta auxiliary protein; HGCN8729; MGC8367; Mutagen-sensitive 209 protein; Pcna/cyclin; PCNAR; Polymerase delta accessory protein; Proliferating Cell Nuclear Antigen |
| 规格价格 | 50ul/860元 购买 100ul/1580元 购买 大包装/询价 |
| 说 明 书 | 50ul 100ul |
| 研究领域 | 肿瘤 细胞生物 细胞周期蛋白 转录调节因子 |
| 抗体来源 | Mouse |
| 克隆类型 | Monoclonal |
| 克 隆 号 | 10E9 |
| 交叉反应 | Human, Mouse, Rat, |
| 产品应用 | WB=1:500-1000 IHC-P=1:400-800 IHC-F=1:400-800 (石蜡切片需做抗原修复) not yet tested in other applications. optimal dilutions/concentrations should be determined by the end user. |
| 分 子 量 | 29kDa |
| 细胞定位 | 细胞核 |
| 性 状 | Lyophilized or Liquid |
| 浓 度 | 1mg/ml |
| 免 疫 原 | KLH conjugated synthetic peptide derived from human PCNA: |
| 亚 型 | IgG |
| 纯化方法 | affinity purified by Protein G |
| 储 存 液 | 0.01M TBS(pH7.4) with 1% BSA, 0.03% Proclin300 and 50% Glycerol. |
| 保存条件 | Store at -20 °C for one year. Avoid repeated freeze/thaw cycles. The lyophilized antibody is stable at room temperature for at least one month and for greater than a year when kept at -20°C. When reconstituted in sterile pH 7.4 0.01M PBS or diluent of antibody the antibody is stable for at least two weeks at 2-4 °C. |
| PubMed | PubMed |
| 产品介绍 | background: Proliferating cell nuclear antigen (PCNA) is a 28kDa nuclear protein associated with the cell cycle, a nuclear protein vital for cellular DNA synthesis. Proliferating cell nuclear antigen was originally identified by immunofluorescence as a nuclear protein whose appearance correlated with the proliferate state of the cell. PCNA is required for replication of DNA in vitro and has been identified as the auxiliary protein (cofactor) for DNA polymerase delta. The anti-PCNA antibodies react with the nuclei of proliferating cells. PCNA is essential for cellular DNA synthesis and is also required for the in vitro replication of simian virus 40 (SV40) DNA where it acts to coordinate leading and lagging strand synthesis at the replication fork. The PCNA protein may fulfil several separate roles in the cell nucleus associated with changes in its antigenic structure. Function: Auxiliary protein of DNA polymerase delta and is involved in the control of eukaryotic DNA replication by increasing the polymerase's processibility during elongation of the leading strand. Induces a robust stimulatory effect on the 3'-5' exonuclease and 3'-phosphodiesterase, but not apurinic-apyrimidinic (AP) endonuclease, APEX2 activities. Has to be loaded onto DNA in order to be able to stimulate APEX2. Plays a key role in DNA damage response (DDR) by being conveniently positioned at the replication fork to coordinate DNA replication with DNA repair and DNA damage tolerance pathways. Acts as a loading platform to recruit DDR proteins that allow completion of DNA replication after DNA damage and promote postreplication repair: Monoubiquitinated PCNA leads to recruitment of translesion (TLS) polymerases, while 'Lys-63'-linked polyubiquitination of PCNA is involved in error-free pathway and employs recombination mechanisms to synthesize across the lesion. Subunit: Homotrimer. Forms a complex with activator 1 heteropentamer in the presence of ATP. Interacts with EXO1, POLH, POLK, DNMT1, ERCC5, FEN1, CDC6 and POLDIP2. Interacts with APEX2; this interaction is triggered by reactive oxygen species and increased by misincorporation of uracil in nuclear DNA. Forms a ternary complex with DNTTIP2 and core histone. Interacts with KCTD10 and PPP1R15A (By similarity). Interacts with POLD1, POLD3 and POLD4. Interacts with BAZ1B; the interaction is direct. Interacts with HLTF and SHPRH. Interacts with NUDT15. Interaction is disrupted in response to UV irradiation and acetylation. Interacts with CDKN1A/p21(CIP1) and CDT1; interacts via their PIP-box which also recruits the DCX(DTL) complex. Interacts with DDX11. Interacts with EGFR; positively regulates PCNA. Interacts with PARPBP. Interacts (when ubiquitinated) with SPRTN; leading to enhance RAD18-mediated PCNA ubiquitination. Interacts (when polyubiquitinated) with ZRANB3. Interacts with SMARCAD1. Interacts with CDKN1C. Interacts with KIAA0101/PAF15 (via PIP-box). Subcellular Location: Nucleus. Note=Forms nuclear foci representing sites of ongoing DNA replication and vary in morphology and number during S phase. Together with APEX2, is redistributed in discrete nuclear foci in presence of oxidative DNA damaging agents. Post-translational modifications: Following DNA damage, can be either monoubiquitinated to stimulate direct bypass of DNA lesions by specialized DNA polymerases or polyubiquitinated to promote recombination-dependent DNA synthesis across DNA lesions by template switching mechanisms. Following induction of replication stress, monoubiquitinated by the UBE2B-RAD18 complex on Lys-164, leading to recruit translesion (TLS) polymerases, which are able to synthesize across DNA lesions in a potentially error-prone manner. An error-free pathway also exists and requires non-canonical polyubiquitination on Lys-164 through 'Lys-63' linkage of ubiquitin moieties by the E2 complex UBE2N-UBE2V2 and the E3 ligases, HLTF, RNF8 and SHPRH. This error-free pathway, also known as template switching, employs recombination mechanisms to synthesize across the lesion, using as a template the undamaged, newly synthesized strand of the sister chromatid. Monoubiquitination at Lys-164 also takes place in undamaged proliferating cells, and is mediated by the DCX(DTL) complex, leading to enhance PCNA-dependent translesion DNA synthesis. Sumoylated during S phase. Acetylated in response to UV irradiation. Acetylation disrupts interaction with NUDT15 and promotes degradation. Phosphorylated. Phosphorylation at Tyr-211 by EGFR stabilizes chromatin-associated PCNA. Similarity: Belongs to the PCNA family. SWISS: P12004 Gene ID: 5111 Database links: Entrez Gene: 515499 Cow Entrez Gene: 5111 Human Entrez Gene: 18538 Mouse Entrez Gene: 25737 Rat Omim: 176740 Human SwissProt: Q3ZBW4 Cow SwissProt: P12004 Human SwissProt: P17918 Mouse SwissProt: P04961 Rat Unigene: 147433 Human Unigene: 728886 Human Unigene: 7141 Mouse Unigene: 223 Rat Important Note: This product as supplied is intended for research use only, not for use in human, therapeutic or diagnostic applications. PCNA是一种仅在增殖细胞中合成或表达的核内多肽,其表达和合成与细胞周期有关。主要表达于增殖细胞的S期、G1期和G2初期。 PCNA主要作为判断各种恶性肿瘤(包括胃肠道癌肿、乳腺癌、肝癌、膀胱癌等)细胞增殖和其恶性程度的一种指标. |
| 产品图片 | ![]() Sample: NIH/3T3 Cell (Mouse) Lysate at 40 ug Primary: Anti-PCNA (bsm-33035M) at 1/1000 dilution Secondary: IRDye800CW Goat Anti-Mouse IgG at 1/20000 dilution Predicted band size: 29 kD Observed band size: 29 kD ![]() Sample: Hela Cell (Human) Lysate at 40 ug Primary: Anti-PCNA (bsm-33035M) at 1/1000 dilution Secondary: IRDye800CW Goat Anti-Mouse IgG at 1/20000 dilution Predicted band size: 29 kD Observed band size: 29 kD ![]() Sample: A431 Cell (Human) Lysate at 40 ug Primary: Anti-PCNA (bsm-33035M) at 1/1000 dilution Secondary: IRDye800CW Goat Anti-Mouse IgG at 1/20000 dilution Predicted band size: 29 kD Observed band size: 29 kD ![]() Paraformaldehyde-fixed, paraffin embedded (Human colon carcinoma); Antigen retrieval by microwave in sodium citrate buffer (pH6.0) ; Block endogenous peroxidase by 3% hydrogen peroxide for 30 minutes; Blocking buffer (3% BSA) at RT for 30min; Antibody incubation with (PCNA) Monoclonal Antibody, Unconjugated (bsm-33035M) at 1:400 overnight at 4°C, followed by conjugation to the secondary antibody (labeled with HRP)and DAB staining. ![]() Paraformaldehyde-fixed, paraffin embedded (Human stomach carcinoma); Antigen retrieval by boiling in sodium citrate buffer (pH6.0) for 15min; Block endogenous peroxidase by 3% hydrogen peroxide for 20 minutes; Blocking buffer (normal goat serum) at 37°C for 30min; Antibody incubation with (PCNA) Monoclonal Antibody, Unconjugated (bsm-33035M) at 1:400 overnight at 4°C, followed by operating according to SP Kit(Mouse) (sp-0024) instructionsand DAB staining. ![]() Paraformaldehyde-fixed, paraffin embedded (Rat liver); Antigen retrieval by boiling in sodium citrate buffer (pH6.0) for 15min; Block endogenous peroxidase by 3% hydrogen peroxide for 20 minutes; Blocking buffer (normal goat serum) at 37°C for 30min; Antibody incubation with (PCNA) Monoclonal Antibody, Unconjugated (bsm-33035M) at 1:400 overnight at 4°C, followed by a conjugated secondary (sp-0023) for 20 minutes and DAB staining. ![]() Paraformaldehyde-fixed, paraffin embedded (Mouse testis); Antigen retrieval by boiling in sodium citrate buffer (pH6.0) for 15min; Block endogenous peroxidase by 3% hydrogen peroxide for 20 minutes; Blocking buffer (normal goat serum) at 37°C for 30min; Antibody incubation with (PCNA) Monoclonal Antibody, Unconjugated (bsm-33035M) at 1:400 overnight at 4°C, followed by a conjugated secondary (sp-0023) for 20 minutes and DAB staining. ![]() Paraformaldehyde-fixed, paraffin embedded (Human stomach carcinoma); Antigen retrieval by boiling in sodium citrate buffer (pH6.0) for 15min; Block endogenous peroxidase by 3% hydrogen peroxide for 20 minutes; Blocking buffer (normal goat serum) at 37°C for 30min; Antibody incubation with (PCNA) Monoclonal Antibody, Unconjugated (bsm-33035M) at 1:400 overnight at 4°C, followed by operating according to SP Kit(Mouse) (sp-0024) instructionsand DAB staining. ![]() Paraformaldehyde-fixed, paraffin embedded (Human liver cancer); Antigen retrieval by boiling in sodium citrate buffer (pH6.0) for 15min; Block endogenous peroxidase by 3% hydrogen peroxide for 20 minutes; Blocking buffer (normal goat serum) at 37°C for 30min; Antibody incubation with (PCNA) Polyclonal Antibody, Unconjugated (bsm-33035M) at 1:400 overnight at 4°C, followed by operating according to SP Kit(Mouse) (sp-0024) instructionsand DAB staining. |
风险提示:丁香通仅作为第三方平台,为商家信息发布提供平台空间。用户咨询产品时请注意保护个人信息及财产安全,合理判断,谨慎选购商品,商家和用户对交易行为负责。对于医疗器械类产品,请先查证核实企业经营资质和医疗器械产品注册证情况。
文献和实验上海西唐生物科技有限公司 021-55229872, 65333639 www.westang.com 人增殖细胞核抗原 (PCNA)ELISA 试剂盒 ( 用于血清、血浆、细胞培养上清液和其它生物体液内 ) 原理 本实验采用双抗体夹心 ABC-ELISA 法。用抗人 PCNA 单抗包被于酶标板上,标准品和样品中的 PCNA与单抗结合,加入生物素化的抗人 PCNA ,形成免疫
上海西唐生物科技有限公司 021-55229872, 65333639 www.westang.com 小鼠增殖细胞核抗原 (PCNA)ELISA 试剂盒 ( 用于血清、血浆、细胞培养上清液和其它生物体液内 ) 原理 本实验采用双抗体夹心 ABC-ELISA 法。用抗小鼠 PCNA 单抗包被于酶标板上,标准品和样品中的 PCNA与单抗结合,加入生物素化的抗小鼠
上海西唐生物科技有限公司 021-55229872, 65333639 www.westang.com 大鼠增殖细胞核抗原 (PCNA)ELISA 试剂盒 ( 用于血清、血浆、细胞培养上清液和其它生物体液内 ) 原理 本实验采用双抗体夹心 ABC-ELISA 法。用抗大鼠 PCNA 单抗包被于酶标板上,标准品和样品中的 PCNA 与单抗结合,加入生物素化的抗大鼠 PCNA ,形成免疫复合物连接在板上
技术资料暂无技术资料 索取技术资料